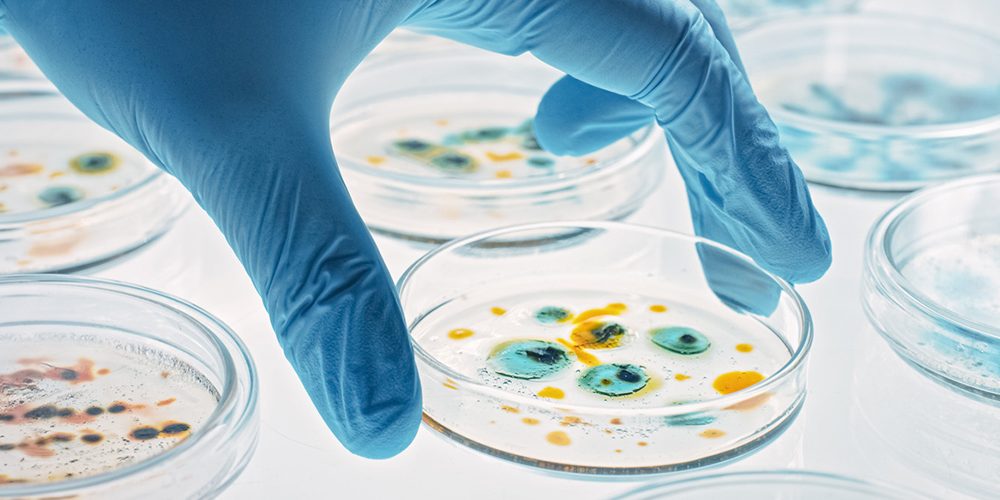

Antimicrobial Stewardship in Assisted Living: Protecting the Most Vulnerable
Antibiotics, thought by some to be the greatest discovery of all time, extending human lifespan by decades, are facing a growing threat: antibiotic resistance. When bacteria develop resistance to these life-saving medications, infections become harder to treat. This leads to more severe illness, hospitalization, and even death. In recent years, there has been increased focus on antimicrobial stewardship in skilled nursing facilities (SNF), however, this is a concern for everyone and equally important in assisted living facilities (ALF).
Prior to moving to their new home within an ALF, residents and their families made the difficult decision that an increased level of care was necessary. Caregivers in ALFs dedicate themselves to the well-being of their residents. This includes protecting them from infection, ensuring they receive the best possible care. But did you know that even the most well-intentioned antibiotic use can sometimes do more harm than good? That’s where antimicrobial stewardship comes in.
The Growing Threat of Antimicrobial Resistance
Studies have shown 40-75% of antibiotic orders in long-term care facilities are deemed to be inappropriate. The overuse and misuse of these life-saving antibiotics have led to a concerning trend: antibiotic resistance, resulting in:
- Increased illness: Resistant bacteria are more difficult to kill, requiring longer and stronger antibiotic courses. As a result, patients tend to remain sicker for longer.
- Increased risk for adverse drug events: The need for longer and stronger antibiotic courses increases the risk for adverse drug events (ADEs) such as cardiac arrhythmias, C. difficile infection, kidney and liver damage, and delirium as well as increased potential for drug-drug interactions.
- Hospitalization: More intensive treatment of either the infection or associated ADEs may be needed.
- Higher healthcare costs: Treating resistant infections is often more expensive than treating infections with readily available antibiotics.
- Death: In some cases, resistant bacteria are untreatable and can be life-threatening.
When discussing the growing threat of antimicrobial resistance with Dr. Galina Shteyman, Antimicrobial Stewardship Consultant Pharmacist with the Healthcare-Associated Infections and Antimicrobial Resistance Section at Minnesota Department of Health and Board-Certified in Pharmacotherapy and Infectious Diseases, she stated, “It is essential to keep up to date on patients’ allergies. The use of second-line and broader-spectrum antibiotics might worsen patient outcomes. Patients’ education about drug allergies and intolerances is crucial to preserving our antimicrobials and decreasing antibiotic resistance.”
Education regarding the difference between drug allergies and intolerance has potential to reduce ADEs, hospitalization, healthcare costs and death.
Why Antibiotic Stewardship is Crucial in ALFs
While antimicrobial stewardship within the SNF setting has become a focus of state and national agencies, it is a concern for everyone and particularly worrisome for residents in ALFs. Here’s why:
- Similar vulnerability: Residents in both ALFs and SNFs are often older adults with compromised immune systems and multiple chronic health conditions. This makes them more susceptible to infections and increases the risks associated with antibiotic overuse.
- Potential for spread: While SNFs may have higher patient densities, ALFs are not without risk. Residents in ALFs are more independent, sharing common areas and having frequent contact with caregivers, creating increased opportunities for bacteria to spread.
- Focus on prevention: ALFs typically provide less intensive care than SNFs. This means a strong focus on infection prevention and control is even more critical to minimize the need for antibiotics in the first place.
Taking Action: Successful Implementation of Antibiotic Stewardship
The good news is that ALF staff can play a vital role in promoting antibiotic stewardship. Here’s how:
- Education is key: Stay informed about the latest guidelines for antibiotic use and educate residents and families about the importance of responsible antibiotic use. This empowers them to ask questions and be advocates for their health.
- Become champions of infection prevention: Implement and participate in infection prevention best practices like hand hygiene, proper cleaning protocols, and resident vaccinations. Strong infection control measures reduce the spread of bacteria.
- Use interdisciplinary communication: Maintain open communication with physicians and other healthcare providers. If there is concern about the necessity of an antibiotic order for a resident, don’t hesitate to ask questions!
- Lead by example: Always follow proper medication administration and monitoring protocols and document antibiotic use accurately. This ensures residents receive the correct medication at the right dose for the right duration.
Empowering Residents and Families
Including residents and families in discussions about antibiotic use is crucial. Dr. Shteyman specifically highlights engaging staff, residents and family on the importance of watchful waiting. “Knowing how challenging the geriatric patient population is, it is crucial to emphasize that starting antibiotics to treat some of the patient’s conditions, such as UTI, based on changes in mental status without any other signs and symptoms of infections can cause more harm than good,” she commented. “Increasing patient and family awareness of this approach [watchful waiting] is the first step in encouraging open communication.”
For tips on how to connect with residents and their families on the importance of antibiotic stewardship read our July blog post on Antimicrobial Stewardship in Assisted Living: Engaging Residents and Families. Educated families can be strong advocates for responsible antibiotic use for their loved ones. Here are some additional strategies:
- Encourage open communication: Make sure residents and families feel comfortable discussing any concerns they may have about antibiotic orders.
- Involve families in decision-making: Ensure staff identify what matters to the resident and their family when it comes to antibiotic use. When appropriate, include families in discussions about treatment options for their loved ones.
- Provide educational materials: Develop pamphlets or presentations that explain the concern about antibiotic overuse and the importance of stewardship. Visit the CDC’s Antibiotic Prescribing and Use Patient Education Resources website for handouts, posters and infographics.
Working Together for Resident Health
By working together, implementing antibiotic stewardship best practices, and educating ourselves and residents, a safer and healthier environment can be created for everyone in ALFs. Remember, protecting residents from antibiotic resistance is an ongoing effort. The dedication to responsible antibiotic use plays a vital role in ensuring the continued effectiveness of these life-saving medications for years to come.
Additional Provider Resources
- The Centers for Disease Control and Prevention (CDC) Core Elements of Outpatient Antibiotic Stewardship: https://www.cdc.gov/antibiotic-use/media/pdfs/Core-Elements-Outpatient-508.pdf
- The Centers for Disease Control and Prevention (CDC) Core Elements of Antibiotic Stewardship for Nursing Homes: https://www.cdc.gov/antibiotic-use/hcp/core-elements/nursing-homes-antibiotic-stewardship.html
- The American Society for Health-System Pharmacists (ASHP) Antibiotic Stewardship Resources:https://www.ashp.org/
- The Society for Healthcare Epidemiology of America (SHEA) Antibiotic Stewardship Resources: https://shea-online.org/
- Minnesota Antimicrobial Stewardship Program Resources for Long-term Care Facilities – MN Dept. of Health (state.mn.us)

Nicole Barnett, PharmD, BCGP – Consultant Pharmacist.
Nicole Barnett is a Board-Certified Geriatric Pharmacist and clinical consultant at Guardian Pharmacy of Minnesota with over 15 years’ experience promoting the health and well-being of our aging population. With focus on age-friendly care, Nicole specializes in medication deprescribing and optimization with a growing passion in the area of pharmacogenomics.